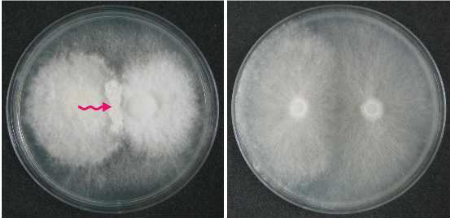
2 _2_

Technical Leadership
Core Team & Tech Evolution
Our company scientists, as the leader of the company’s technical team, holds a Ph.D. from Western California Medical University and has over 30 years of research and development experience in the field of biotechnology. He has dedicated more than 18 years to the research and development of new mycelial strains such as Efila, possessing globally leading technology in this area. He has published numerous academic papers on the therapeutic mechanisms and properties of new strains and holds 8 invention patents. Our company scientists has also received multiple international awards, including the EURO INVENT Award. Additionally, he serves as a member of the Korean Technology Assessment Committee.
Through multiple studies, it has been confirmed that the EFILA strain culture exhibits effectiveness in managing diabetes and liver diseases, while also stabilizing the body's endocrine system and enhancing immunity. By leveraging a combination of synthetic biology and traditional breeding methods such as hybridization and mutagenesis, our technical team has developed a strain that is suitable for cost-effective and scalable manufacturing.
First-Generation Strain: Ceriporia lacerata
In August 2005, our technical team discovered a unique fungal strain demonstrating significant anti-diabetic properties while conducting research on bioactive compounds in medicinal mushrooms. This strain, isolated from a mushroom sample collected in Korea, was characterized as Ceriporia lacerata through DNA sequencing and phylogenetic analysis. However, the cultivation of the first-generation strain presented challenges due to its prolonged growth cycle (9-10 days) and high susceptibility to contamination, resulting in a cultivation success rate of only 20-30%.
Second-Generation Strain: Ceriporia lacerata K1
To address the limitations associated with the first-generation strain, a second-generation strain was developed through hybridization. This new strain, which was deposited with the Korean Agricultural Culture Collection (KACC) in June 2018, was subsequently reclassified as Ceriporia lamaritus. Ceriporia lamaritus exhibits comparable anti-diabetic effects to its predecessor while demonstrating a significantly reduced cultivation cycle (5-6 days), enhanced resistance to contamination, achieving a 100% cultivation success rate, and improved economic viability for large-scale production.
 | |
Third-Generation Strain: Irpex lacteus f.k (Pre-commercial)
This strain was developed from Ceriporia lamaritus through ethyl methanesulfonate (EMS)-induced mutagenesis, which introduced random genetic mutations. This process facilitated the isolation of a superior strain, Irpex lacteus f.k., which has been deposited with the Korean Agricultural Culture Collection (KACC) and designated as EFILA for its mycelial culture. This new strain exhibits significant enhancements in growth cycle duration, contamination resistance, and cultivation efficiency compared to previous generations.





